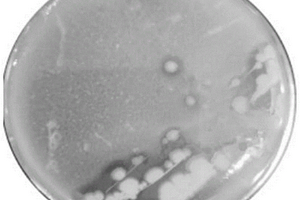

全部

 926
926
 0
0
本发明一种铝电解槽阴极保温层结构,主要应用于铝电解槽结构的设计、技术装备的制造以及铝电解槽的生产。其特征是:在对铝电解槽阴极炭块底部实施保温隔热层构造时,用氧化铝或电解质,作为构筑铝电解槽槽壳体水平底板上部和阴极炭块底部之间的保温隔热层的构筑材料,以期在进行铝电解槽槽大修时,所形成产生的大修固废渣料,可不经过无害化工艺处理,就能直接应用于电解铝的生产过程。以便从源头上解决产生铝电解槽大修危固废渣问题,减少铝电解槽危险固废排放量,降低企业危固废处理成本、保护生态环境的目的。

 810
810
 0
0
本实用新型公开了一种生产高纯度二氧化氯气体的装置,该装置的发生器与硫酸管、双氧水管及氯酸钠管相接,发生器连接母液排放槽;蒸发结晶器与加热器之间形成循环回路,该回路与母液排放槽相通,母液下循环管与过滤装置连接并形成回路,过滤装置出口连接干燥器;蒸发结晶器与发生器入口相接,该管路上安装有母液罐。本实用新型装置采用双氧水作为还原剂,利用发生器制取二氧化氯时,采用空气对反应液进行曝气搅拌,并对制出的二氧化氯气体进行稀释,连续生产出纯度高、水分含量少的二氧化氯气体;同时利用蒸发结晶器、干燥器对产生的副产品芒硝进行蒸发结晶、过滤、烘干,制成元明粉。采用本实用新型装置,使得整个生产过程无固体废弃物和废液产生。

 901
901
 0
0
本实用新型公开了一种防堵沉淀器,该沉淀器的一侧设有进水口和配水槽,另一侧设有出水槽和排水口,中部设有沉淀槽,沉淀槽的上部设有斜板,斜板的顶部设有出水控制堰槽,出水控制堰槽与出水槽之间由出水管相连接,出水槽的底部设置排水口,配水槽与沉淀槽之间设有相通的整流布水系统,配水槽的侧边设置进水口;沉淀槽的下部设有液下刮泥机、污泥斗和均布式排泥系统,均布式排泥系统与污泥斗相通。本实用新型结构紧凑、造价低、斜板耐腐蚀性能较强、液下传动部件较少、运行稳定可靠,能有效防止污泥堵塞斜板,可对污泥浓度较高的废水进行固液分离,去除废水中的固体杂质。

 971
971
 0
0
一种环保式垃圾处理器固液分离装置,包括漏液板、分液板、分液管、转动杆、滚动轴承二、复位弹簧二、积液瓶,漏液板与分液板相连接,两板间有一定的空隙,分液板左下部与分液管相连,积液瓶的上端与分液管相接,转动杆的中部与分液板的底部相固定。本发明可以实现在压缩垃圾时垃圾中的液体与固体垃圾的分离,垃圾中的废液可通过固液分离装置收集到积液瓶中,减少了垃圾存放过程中废液产生的臭气。

 1096
1096
 0
0
本发明公开一种碳量子点的制备方法,包括将含碳前驱体置于超声波清洗机中清洗,然后烘干,得干燥物;将干燥物置于高压反应釜,加入NaOH溶液,密闭,然后将高压反应釜置于烘箱中进行水热反应;待高压反应釜冷却后取出,将高压反应釜内的混合液用双层滤纸过滤,得滤液;将滤液离心,过滤,得上清液;将上清液装入透析袋中透析;将透析袋内的透析液放入冷冻干燥箱中冷冻干燥,即得固体碳量子点。本发明采用来源广泛且经济环保的废纸、碎布或废棉作为含碳前驱体,采用水热法制备,经过过滤、离心、透析等步骤,得到的碳量子点产率高、结构均匀、分散性好。

 896
896
 0
0
本发明公开了一种棘孢木霉菌肥及其制备方法,以糖蜜酒精浓缩液和豆泥为原料生产棘孢木霉菌肥,原料完全采用工厂废弃物,实现废弃物资源化利用,且制备方法简单,制得的棘孢木霉菌肥对植物生长具有促进作用;方法具体包括如下步骤:(1)取保藏的棘孢木霉原种经多次划线分离出单菌落;(2)挑取单菌落接种于糖蜜酒精浓缩液培养基中进行活化培养,得到活化棘孢木霉菌;(3)将活化棘孢木霉菌接种至液体培养基中进行液体扩大培养,得到棘孢木霉液体菌种;(4)将棘孢木霉菌液体菌种接种至豆泥固态培养基中,搅拌均匀后平铺进行固态培养,得到固态培养物;(5)将固体培养物低温烘干,然后粉碎或造粒得到棘孢木霉菌肥。

 728
728
 0
0
本发明公开了一种可修复板结土壤的方法,包括:步骤(1)收集树上掉落的树叶、修剪树木时得到的树枝树叶以及厨房垃圾中未沾油污的蔬菜水果垃圾,与牛羊粪便混合;浸泡;步骤(2)禽畜养殖废水与蔬菜水果垃圾的重量比为9~10:1,加入土壤有益菌;发酵;步骤(3)发酵液与禽畜养殖废水的重量比为1:50~55,进行厌氧发酵;步骤(4)在土壤上打多个组合孔,之后将发酵固体物填入组合孔内,再将发酵液态物反复淋浇在土壤的表面;将秸秆铺在土壤表面,在秸秆上再淋浇发酵液态物;覆盖地膜;向组合孔投放蚯蚓,再覆盖上地膜,待2~3天揭开地膜。本发明缩短了土壤修复的时间,降低了成本,并且具有良好的修复效果。

 1182
1182
 0
0
一种城市密集人口区域的垃圾和沼气综合处理方法,可将城市中大量厌氧池的沼气收集,集中输送至垃圾焚烧炉中,作为垃圾燃烧助燃剂使用;此举既可以解决厌氧池沼气污染城市环境,又可以节省垃圾焚烧所使用的煤、油和天然气等助燃剂。从根本上改善了城市固体废物、城市废气的环境问题。
944
944
 0
0
本发明涉及微生物酶技术领域。本发明提供了一株副短短芽孢杆菌Gxun‑20及其应用,所述副短短芽孢杆菌Gxun‑20保藏名称为Brevibacillusparabrevis Gxun‑20,拉丁文为Brevibacillusparabrevis,保藏日期:2019年6月13日,保藏单位:广东省微生物菌种保藏中心,保藏编号:GDMCC No:60686。本申请的副短短芽孢杆菌Gxun‑20抗逆性强、角蛋白酶产量高、产生的酶活性高,能够高效降解羽毛。不仅利用了废弃蛋白资源,缓解了目前蛋白资源紧张问题,而且对治理羽毛类固体废弃物污染,保护环境具有积极意义。

 974
974
 0
0
本发明公开了一种具有生物除臭功能的垃圾堆肥系统,它属于有机固体废弃物处置和资源化利用技术领域。它主要由堆肥槽和生物除臭覆盖装置构成,所述堆肥槽中堆放垃圾堆料,堆肥槽的底部设有多根曝气管道,曝气管道与鼓风机相连接;所述生物除臭覆盖装置覆盖于堆肥槽上并将垃圾堆料进行覆盖;所述堆肥槽的侧壁上设有氧气传感器、温度传感器和控制器,氧气传感器、温度传感器和鼓风机均与控制器电性连接,实现自动调节曝气量。本发明适用于垃圾填埋场、垃圾露天堆放场及其他各种废弃物堆放场,采用滑动式的覆盖辅助装置将生物除臭覆盖装置覆盖在堆肥槽上,在堆肥的同时也能很大程度地去除该过程中产生的臭气。

 1027
1027
 0
0
本发明提供了一种生活垃圾高温热解气化处理系统及工艺,其中生活垃圾高温热解气化处理系统包括无轴螺旋烘干输送机、高温热解气化炉、水‑气换热器、旋风除尘器等一系列设备,生活垃圾高温热解气化处理工艺包括垃圾烘干进料、垃圾高温热解气化燃烧、高温尾气急速冷却处理、尾气净化处理、固体废物和液体废物的处理等五大步骤。本发明的设备选用及工艺流程设计合理,垃圾进料控制精确,烘干效果好,垃圾高温热解气化燃烧温度高且时间长,能有效分解二噁英等各种有毒有害气体,高温尾气采用急速冷却处理,避免二噁英再次合成;尾气净化处理时,有针对性地对尾气中的各种灰尘、水汽和有毒有害物质进行吸收和无害化处理,可实现尾气零污染排放。

 1117
1117
 0
0
本发明涉及一种污泥甘蔗渣活性炭及其制备方法,利用污水处理污泥和制糖工业废弃物甘蔗渣制备污泥甘蔗渣活性炭。污泥中添加甘蔗渣,提高污泥的含碳量,提升污泥基活性炭的吸附性能,解决了污泥基活性炭吸附性能较差的问题;通过将污泥进行重金属脱除,提高污泥基活性炭的使用安全性。工艺包括:采用一定的技术手段对污泥进行重金属脱除,将污泥和甘蔗渣烘干后以一定的比例混合均匀,加入一定浓度的活化剂ZnCl2溶液进行浸渍活化,而后在惰性气体保护下热解,洗涤干燥后即得活性炭。本发明利用污泥和甘蔗渣制备活性炭,不仅制备出吸附性能较好的活性炭,还同时对两种工业固体废弃物进行资源化利用,具有良好的经济效益、社会效益和生态效益。

 1135
1135
 0
0
一种家用垃圾的液体分离收集装置,包括漏液板、分液板、分液管、转动杆、滚动轴承二、复位弹簧二、积液瓶,漏液板与分液板相连接,两板间有一定的空隙,分液板左下部与分液管相连,积液瓶的上端与分液管相接,转动杆的中部与分液板的底部相固定。本发明可以实现在压缩垃圾时垃圾中的液体与固体垃圾的分离,垃圾中的废液可通过固液分离装置收集到积液瓶中,减少了垃圾存放过程中废液产生的臭气。

 1053
1053
 0
0
本发明公开了一种生产高纯度二氧化氯气体的方法及装置,该装置的发生器与硫酸管、双氧水管及氯酸钠管相接,发生器连接母液排放槽;蒸发结晶器与加热器之间形成循环回路,该回路与母液排放槽相通,母液下循环管与过滤装置连接并形成回路,过滤装置出口连接干燥器;蒸发结晶器与发生器入口相接,该管路上安装有母液罐。本发明方法采用双氧水作为还原剂,利用发生器制取二氧化氯时,采用空气对反应液进行曝气搅拌,并对制出的二氧化氯气体进行稀释,连续生产出纯度高、水分含量少的二氧化氯气体;同时利用蒸发结晶器、干燥器对产生的副产品芒硝进行蒸发结晶、过滤、烘干,制成元明粉。本发明整个生产过程无固体废弃物和废液产生。

 836
836
 0
0
本发明公开了一种土壤板结化的治理方法,包括:收集树上掉落的树叶、修剪树木时得到的树枝树叶以及厨房垃圾中未沾油污的蔬菜水果垃圾,与牛羊粪便混合;浸泡;禽畜养殖废水与蔬菜水果垃圾的重量比为9~10:1,加入土壤有益菌;发酵;发酵液与禽畜养殖废水的重量比为1:50~55,进行厌氧发酵;在土壤上打多个组合孔,之后将发酵固体物填入组合孔内,再将发酵液态物反复淋浇在土壤的表面;点燃待全部秸秆开始燃烧,在秸秆上再淋浇发酵液态物,浇熄火焰;趁秸秆的温度未降低至室温,在秸秆之上覆盖地膜,待10~15天后揭开地膜;向组合孔投放蚯蚓,再覆盖上地膜。本发明缩短了土壤修复的时间,降低了成本,并且具有良好的修复效果。

 939
939
 0
0
本发明涉及固体废弃物利用技术领域,尤其涉及一种泡沫陶瓷及其制备方法。本发明提供的泡沫陶瓷,由包括以下重量份的原料制备得到:半焦50~70份,赤泥20~40份,长石3~15份,分散剂2~10份。本发明以半焦和赤泥为原料,使得半焦和赤泥得到了充分的利用,实现了废弃物的资源化利用。根据实施例的记载,本发明所述的泡沫陶瓷的体密度为300~700kg/m3,气孔率为50~80%,抗压强度为7~10MPa。本发明所述泡沫陶瓷的制备方法成本低,操作容易,能耗低,环保,有利于工业化生产。

 1027
1027
 0
0
本发明公开了一种免深耕的土壤板结处理方法,包括:收集树上掉落的树叶、修剪树木时得到的树枝树叶以及厨房垃圾中未沾油污的蔬菜水果垃圾,与牛羊粪便混合;浸泡;禽畜养殖废水与蔬菜水果垃圾加入土壤有益菌;发酵;发酵液与禽畜养殖废水进行厌氧发酵;在土壤上打多个组合孔,将发酵固体物填入组合孔内,再将发酵液态物反复淋浇在土壤的表面;点燃待全部秸秆开始燃烧,在秸秆上再淋浇发酵液态物,浇熄火焰;趁秸秆的温度未降低至室温,覆盖地膜;向组合孔投放蚯蚓,再覆盖上地膜;向土壤表面洒上草籽,每天向土壤上喷水,直至草籽发芽,翻土,将刚发芽的草翻入土壤内。本发明缩短了土壤修复的时间,降低了成本,并且具有良好的修复效果。

 1072
1072
 0
0
一种气体活塞式排水设备,包括安装在井下的柱状泵和以及带有以压缩空气作动力的气动电磁感应装置,所述的柱状泵泵体上部有进水管和出水管,所述的柱状泵体内部设置有中心管并穿出顶部连接进水管和出水管;所述的气动电磁感应装置包括电磁阀、永磁块和浮动液位感应器,永磁块和浮动液位感应器安装在柱状泵体的中心管外壁上,电磁阀安装在柱状泵体上部的中心管外并连接有压缩空气管,柱状泵泵体中部设有进、补气口,电磁阀压缩空气气体出口管接柱状泵的进、补气口。本设备适合在存在易燃易爆气体、液体腐蚀性强的环境中作业,可用于垃圾填埋气采集、高浓度有机废水处理、有机固体废物厌氧处理等综合利用系统,作为气水分离的排水设备。

 863
863
 0
0
一种木质纤维素酯基氧化催化剂的机械活化固相制备方法,该制备方法将纤维质固废物干燥、粉碎得到纤维质固废物粉末后,按纤维质固废物粉末、酯化剂及助剂100:5-40:1-8的比例加入到混合机混合均匀,得到混合物;然后将上述混合物磨介质堆体积按照100g:200-600ml的比例加入机械活化固相反应器中,在转速为200-600rpm和30-60℃恒温水浴温度下进行球磨反应,达到0.5-1.5h活化时间后,停止搅拌,取出酯化产物和磨球,并将它们分离,得到木质纤维素酯混合物;造粒成球即可得到木质纤维素酯基氧化催化剂。该催化剂不含重金属,不仅具有催化、活化氧化的功能,同时还具有吸附功能,能选择吸附重金属和提高脱色效果,同时由于原料为固废物且制备工艺简单,成本低,添加量少。

 991
991
 0
0
本发明公开了一种防堵塞防腐蚀的超临界水氧化处理装置。高浓度高含盐有机废水及污泥在通过废水泵进入预热器,预热器出口进入反应器,反应器为蒸发壁式反应器,侧面由高压净水泵和高压腐蚀缓蚀剂泵输入净水及缓蚀剂。高压燃料泵将燃料或燃料与水的混合物泵入反应器。反应器出口的后续管路为双管结构,后续管路上设置进料预热器、回热器及高压气液分离器;软水通过高压软水泵泵入回热器,产蒸汽实现热量回收,最后高压气液分离器通过气体降压阀、液体降压阀和固体降压阀实现气相、液相和固相的降压外排。本系统通过加热氧化剂、蒸发壁反应器、低温物料入射、亚临界出料、缓释剂的添加及双管结构流程等方法,有效地提升了系统的防堵塞防腐蚀能力。本发明系统可以广泛应用于高含盐高浓度有机废水及污泥的无害化处理过程。

 1200
1200
 0
0
本发明提供的一种环保复合新型材料的制备方法,采用麦饭石和玄武岩为固体填料,配合胶黏剂,粘合,形成填充料的前驱体;通过逐步高压处理,形成高硬度的填充料;将废弃的布料作为原料,在其包覆无机复合材料,并通过高温烧结,形成硬质材料,提高材料的机械强度,增加了材料的抗冲击能力;在硬质材料外部附着纳米粒子,由于其均匀分布在第一骨料表面,形成第二骨料;这样既能有效的材料的整体机械强度,又能有效的防止纳米粒子团聚;采用两种高硬度的填料和第二骨料,配合不同的粒径,大大的提高了复合材料的抗冲击强度;本申请变废为宝,将碎布等废弃的原料与塑料结合,绿色环保。

 953
953
 0
0
本发明涉及一种氮掺杂有序介孔炭催化剂及其制备方法与应用,所述氮掺杂介孔碳催化剂的制备方法包括以下步骤:以造纸污泥为前驱体,SBA‑15为模板剂,并加入氮源,采用硬模板法制备得到介孔炭材料。本发明还基于高级氧化技术的原理,通过吸附协同催化的方式,将过硫酸盐(PS)作为氧化剂,介孔炭材料为催化剂,通过介孔炭材料活化过硫酸盐产生大量的氧化自由基降解废水中的对硝基苯酚,降解效率达到90%以上。因此,本发明所提供的催化剂的制备方法简单、反应活性高,为废水中难降解有机污染物的去除提供了新技术,也为造纸污泥的资源化利用提供了新的途径,实现对造纸污泥固体废弃物的资源化利用,符合环境经济学以及绿色化学,具有良好的应用前景。

 848
848
 0
0
本实用新型提供了一种生活垃圾资源化的处理系统,属于垃圾处理工艺领域,本实用新型处理系统包括用于浸泡垃圾并利用微生物菌发酵垃圾的除臭池;用于撕开垃圾袋的破袋机;用于对经过破袋机暴露出的垃圾进行清洗筛分,分选出无机物废品和有机质的清洗筛分装置;用于回收分选出的无机物废品中的可回收资源的回收装置;以及用于分离有机质为第一固体有机质和液体有机质,并利用微生物菌发酵第一固体有机质得到固态有机肥,利用微生物菌发酵液体有机质得到液态有机肥的制肥装置。本实用新型利用微生物菌对垃圾进行处理,使其无臭无害;对垃圾进行分选,充分回收其中的可回收资源,处理成本低,对环境的污染少,而且能够极大减少资源浪费。

 926
926
 0
0
本实用新型公开了一种固液分离式运输装置,涉及运输装置技术领域,解决了固体废物处理不便的问题,其技术方案要点是:其包括有第一运输轨道、与第一运输轨道垂直相接的第二运输轨道、驱动机构以及运输箱体;第一运输轨道上沿其长度方向设置有等待工位、接收工位以及处理工位;第二运输轨道位于第一运输轨道的等待工位的侧部;运输箱体挂设在第二运输轨道上并随着第二运输轨道的移动能够放置在第一运输轨道上;第一运输轨道转动时运输箱体从等待工位进入接收工位,运输箱体在第一运输轨道的转动下移动至处理工位。本实用新型具有集收集与运输为一体的优点,能够实现自动化收集固体废物并进行运输至存放点的目的,节省人力以及简化垃圾处理流程。

 1049
1049
 0
0
本发明公开了一种建筑垃圾再生骨料路面砖的制备方法,所述建筑垃圾再生骨料路面砖包括以下原料:建筑垃圾、赤泥、矿渣、水泥、脱硫石膏、复合添加剂,经过制备再生骨料、制备胶凝材料、成型、养护等步骤制备成建筑垃圾再生骨料路面砖。本发明通过利用建筑垃圾、赤泥、矿渣、脱硫石膏等固体废弃物制备路面砖、路沿石等,具有强度高、无污染、产品性能稳定等优点,同时可消耗大量固体废弃物。

 880
880
 0
0
本发明公开了一种苦瓜栽培基质,包括以下体积份的原料:菇渣40~60份、竹屑10~20份、滤泥15~30份、农家肥5~15份、蛭石5~10份。本发明苦瓜栽培基质,采用菇渣、竹屑、滤泥等作为基质的主要原料,该原料均为有机固体废弃物料,解决了有机固体废弃物料的处理问题、更加环保,同时降低基质的生产成本。栽培基质采用各种有机物质复配、能为植物生长提供充足的营养。同时提高苦瓜植株的株高、地上干重和根干重,显著促进苦瓜幼苗生长。本发明苦瓜栽培基质的制备方法,其生产周期短、工艺简单、操作方便、适宜推广应用。

 864
864
 0
0
本发明提供一种全有机栽培基质,包括以下体积份的原料:竹屑20~40份,甘蔗渣20~40份,牛粪5~15份。本发明是先用竹屑和好氧发酵菌发酵一段时间,再与甘蔗渣和牛粪混合进行陈化后得到全有机栽培基质,用本发明的全有机栽培基质培育的种苗成活率高、长势好;利用的竹屑和甘蔗渣是生产加工产生的有机固体废弃物,不仅解决了有机固体废弃物料的处理问题,还更加环保,同时降低了生产成本;基质制备工艺简单、操作方便、适宜推广应用。

 716
716
 0
0
本发明提供一种桉树育苗栽培基质,包括以下体积百分比的原料:稻壳40%~60%,椰糠10%~30%,甘蔗渣10%~30%,牛粪5%~15%,滤泥10%~20%,珍珠岩1%~5%。本发明先用稻壳和甘蔗渣、牛粪、滤泥与好氧发酵菌发酵一段时间,再与椰糠混合进行陈化,加入椰糠甘蔗渣之后有利于稻壳和牛粪的更好的发酵,经过陈化后与珍珠岩混合得到桉树育苗栽培基质,在基质中加入稻壳使基质透气,有利于桉树的生长,用本发明的桉树育苗栽培基质培育的树苗成活率高、长势好;利用的稻壳、椰糠和甘蔗渣是生产加工产生的有机固体废弃物,不仅解决了有机固体废弃物料的处理问题,还更加环保,同时降低了生产成本;桉树育苗基质制备工艺简单、操作方便、适宜推广应用。
中冶有色为您提供最新的广西南宁有色金属环境保护技术理论与应用信息,涵盖发明专利、权利要求、说明书、技术领域、背景技术、实用新型内容及具体实施方式等有色技术内容。打造最具专业性的有色金属技术理论与应用平台!
 2025年10月15日 ~ 17日
2025年10月15日 ~ 17日  2025年10月17日 ~ 19日
2025年10月17日 ~ 19日  2025年10月23日 ~ 25日
2025年10月23日 ~ 25日  2025年10月31日 ~ 11月02日
2025年10月31日 ~ 11月02日  2025年11月07日 ~ 09日
2025年11月07日 ~ 09日 
